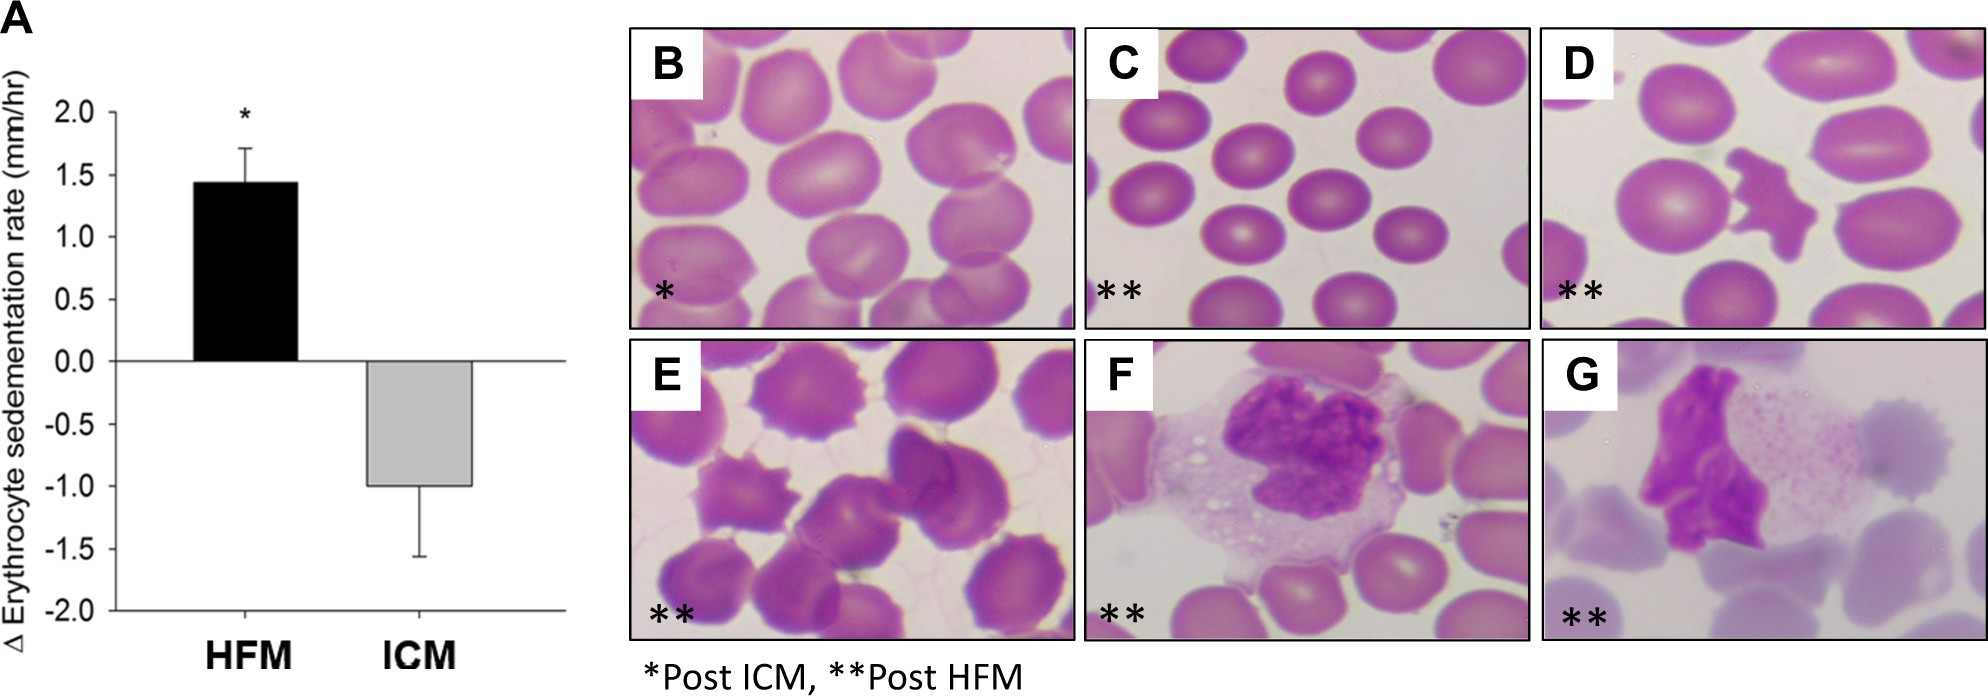
Fig. 2

Fig. 2
Changes in erythrocyte morphology and blood monocytes following HFM. a Effects of HFM and ICM on changes in erythrocyte sedimentation rate. Effects of ICM (b) and HFM (c–e) on RBC morphology. Note the appearance of microcytosis (c), acanthocytosis (d), and echinocytosis (e) following HFM. Foamy monocytes (f) and lipid-laden monocytes (g) post HFM. b–e ×400 magnification, f–g ×1000
